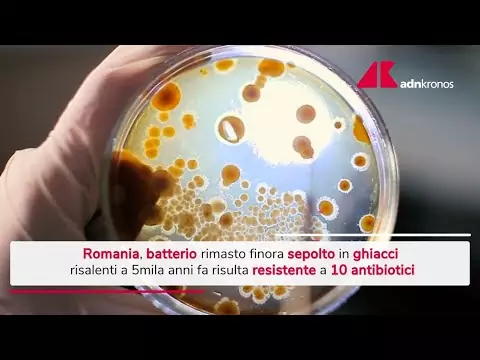
Romania, trovato in una grotta batterio di 5mila anni fa

È rimasto sepolto in ghiacci risalenti a 5mila anni fa. Eppure risulta resistente a 10 antibiotici moderni tra quelli più comunemente utilizzati: si tratta di un batterio trovato nella Grotta ghiacciata di Scarisoara, in Romania. La scoperta, pubblicata sulla rivista Frontiers in Microbiology, potrebbe aiutare a comprendere meglio come si è evoluto il fenomeno dell’antibiotico-resistenza, uno dei principali problemi di salute pubblica che causa oltre 35mila morti all’anno in Europa.
© RIPRODUZIONE RISERVATA